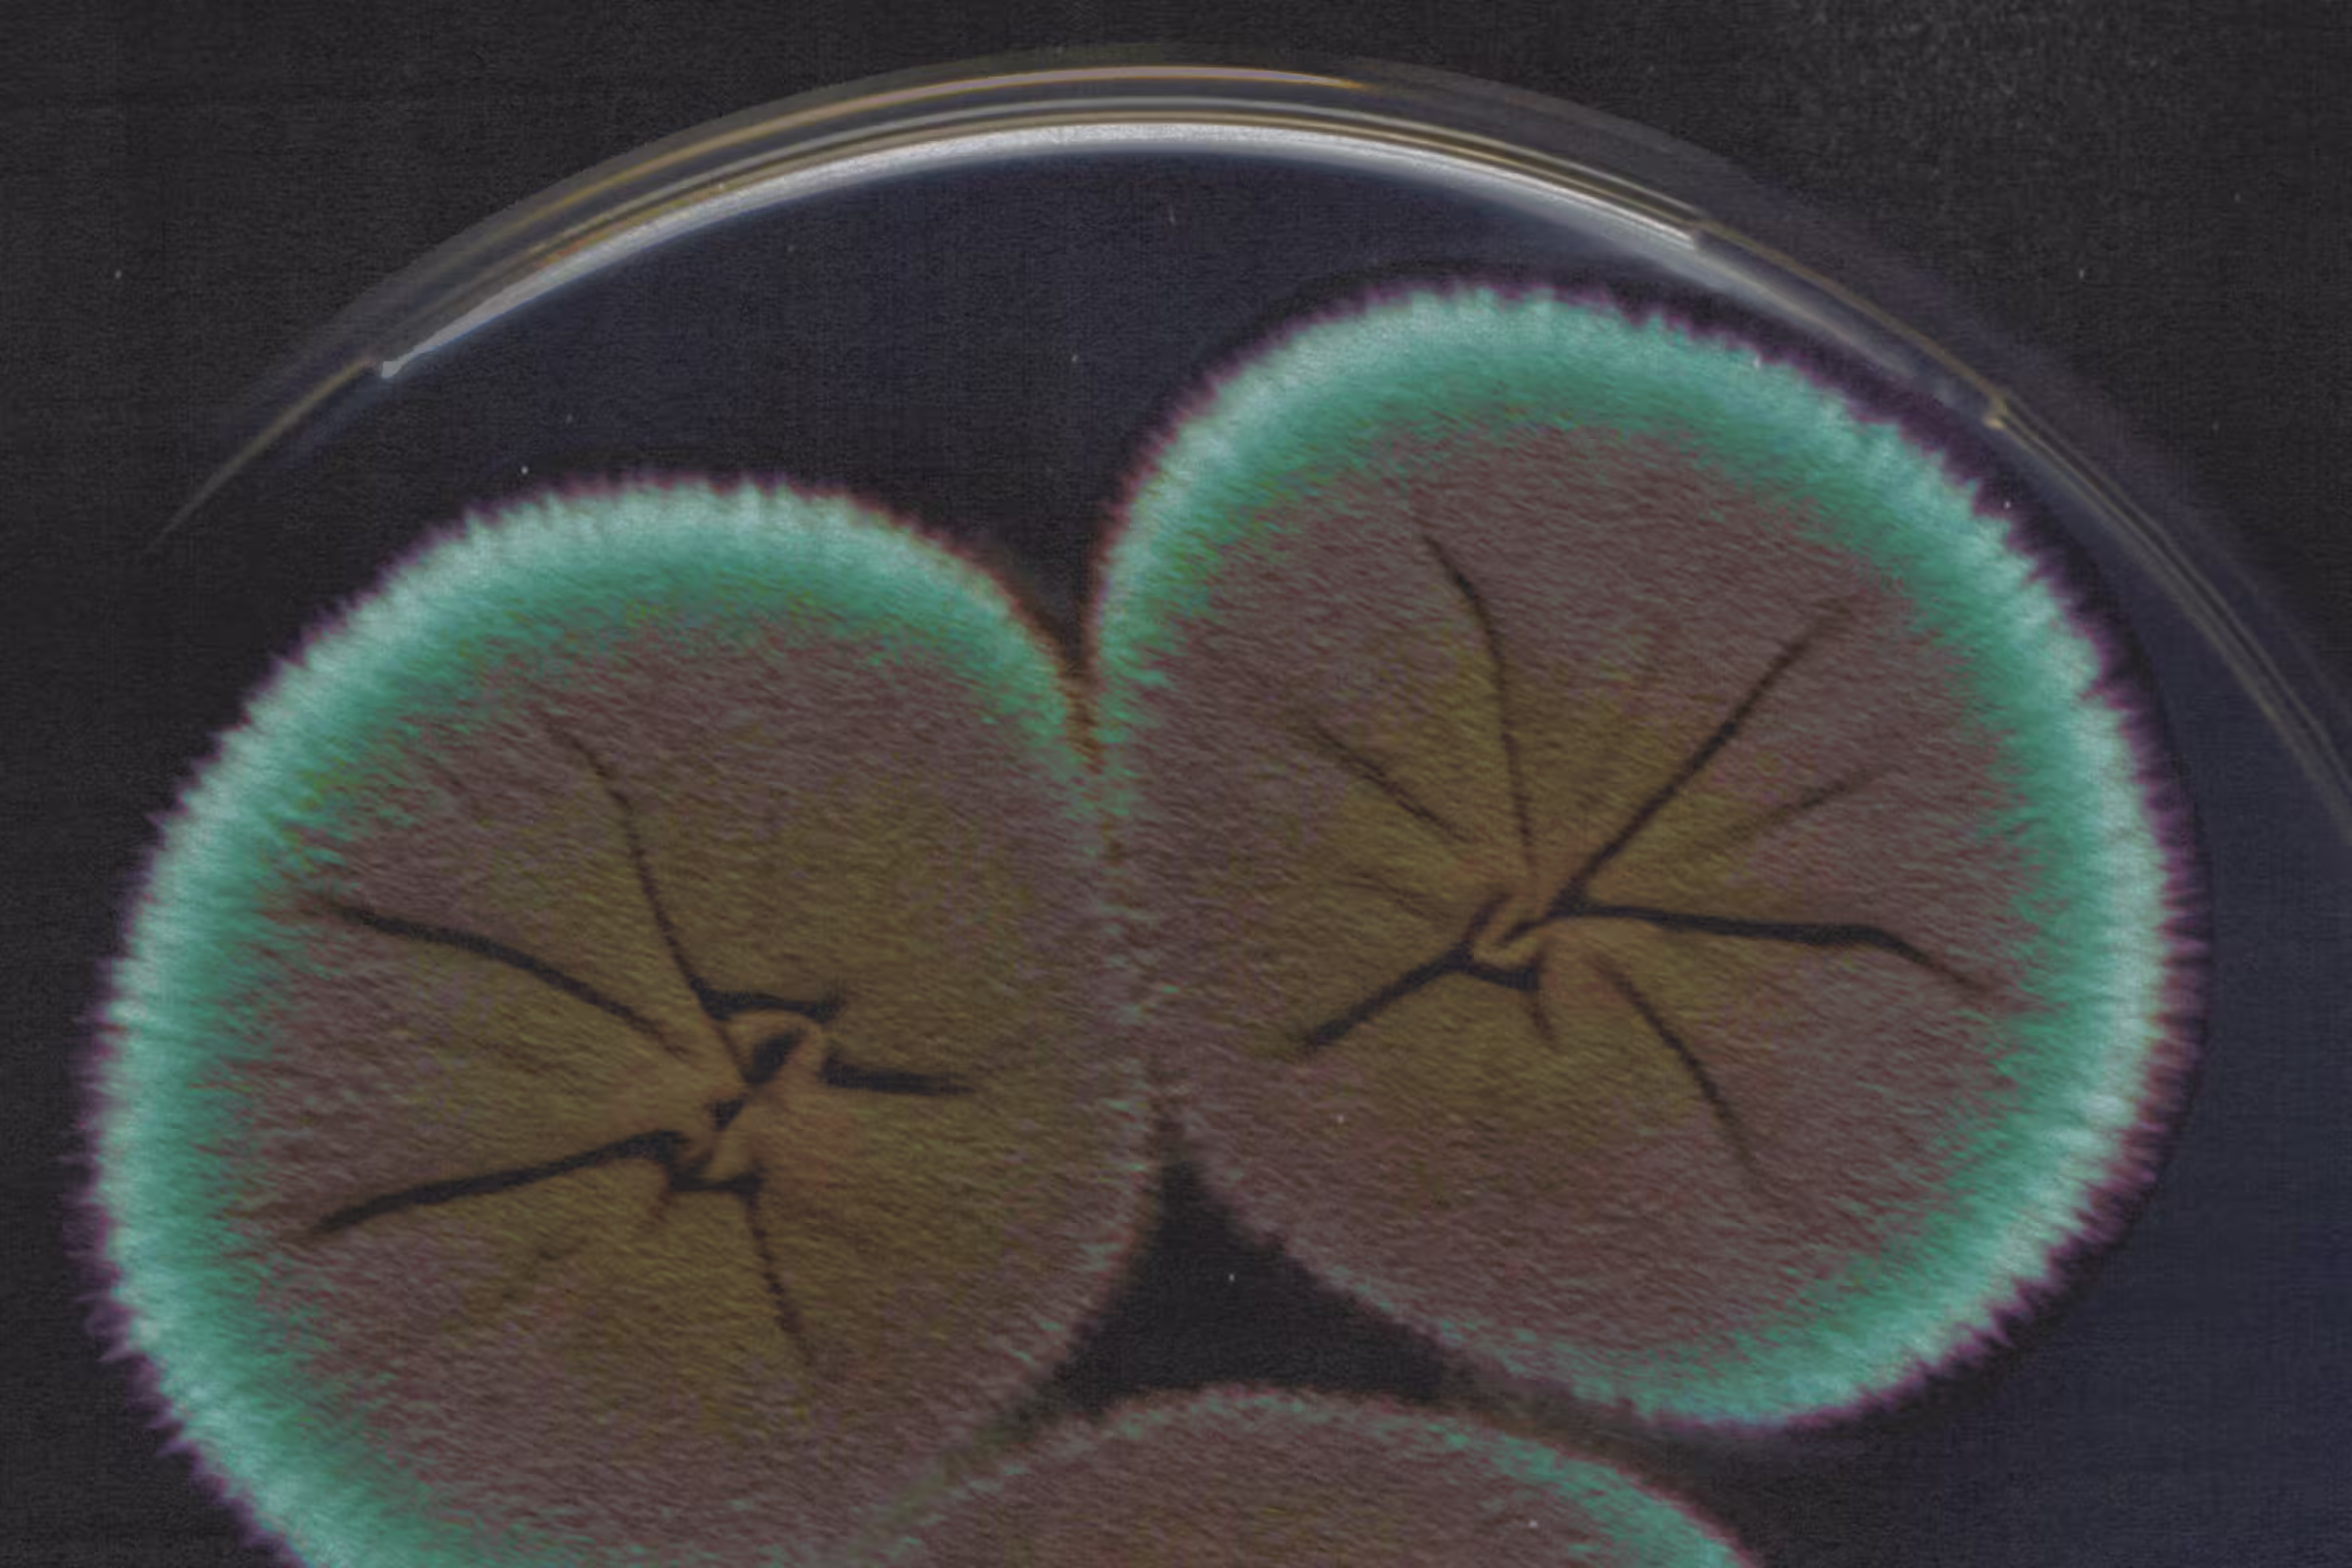

If you’ve been trying to conceive but haven’t had any luck — and your doctor can’t pinpoint an obvious cause — you may be diagnosed with unexplained infertility.
Infertility is defined as the inability to conceive after one year of trying (or six months if you’re 35 or older). Normally, fertility tests identify issues such as ovulation problems, sperm abnormalities, or reproductive health conditions. However, in cases of unexplained infertility (also known as idiopathic infertility), all standard tests return normal results, leaving you with more questions than answers. Basically, you have no identifiable medical problems and everything is working as it should be, but no matter how hard you try, you can’t get pregnant. Unexplained infertility accounts for as many as 30% of cases where a couple struggles to conceive naturally.
A diagnosis of unexplained infertility can be frustrating and disappointing, but it doesn’t mean pregnancy is impossible. Getting pregnant is still possible, even if you've been told you have unexplained infertility. While success rates vary, one study showed that about 21% of couples diagnosed with unexplained infertility were able to conceive naturally. Other research found that around 50% of couples with unexplained infertility will become parents within a year, with another 12% doing so in the following year.
What hidden factors may cause unexplained infertility?
Although doctors may not be able to identify the exact cause, unexplained infertility doesn’t mean there isn’t an underlying issue — it’s simply unknown. Some potential contributing factors may include:
- Subtle hormonal imbalances
- Mild endometriosis
- Egg or sperm quality issues that standard tests don’t detect
- Problems with embryo implantation
- Unrecognized immune system factors
- Vaginal microbiome imbalance
- Environmental or lifestyle influences.
Medical research is continuously evolving, and doctors are learning more about lesser-known causes of fertility challenges.
An emerging explanation could be linked to the vaginal microbiome, which plays a crucial role in reproductive health. When the balance of bacteria in the vagina is off, it can lead to inflammation and increase the risk of infections, creating a less hospitable environment for conception. Studies have shown that imbalances in the vaginal microbiome can contribute to infertility, repeated pregnancy losses, and preterm births. Meanwhile, having a healthy microbiome dominated by protective bacteria isn linked to better fertility, successful implantation, and more positive pregnancy outcomes. While there’s still much to learn about how the vaginal microbiome affects fertility, testing it might be a helpful new tool to enhance your chances of reproductive success.

Recurrent symptoms? Get Evvy's at-home vaginal microbiome test, designed by leading OB-GYNs.
How is unexplained infertility diagnosed?
Unexplained infertility is a diagnosis of exclusion, which means all known causes must first be ruled out. A diagnosis is only made after all standard fertility tests return normal results, yet conception still doesn’t occur despite regular, unprotected intercourse for the recommended time frame (12 months, or six months if you’re over 35).
This diagnosis can feel frustrating and emotionally draining, as there isn’t a single problem to “fix.” However, it’s important to remember that “unexplained” does not mean “untreatable.” Understanding how this diagnosis is reached — and where standard testing may fall short — can help you take informed next steps in your fertility journey.
Standard fertility testing protocols
Before unexplained infertility is diagnosed, your doctor will run a series of standard tests. For women, these typically include:
- Hormone panels (FSH, LH, progesterone, thyroid)
- AMH testing to measure ovarian reserve
- Ultrasounds to assess the ovaries and uterus
- Physical exams to rule out structural issues.
For men, a semen analysis is performed to evaluate sperm count, motility, and morphology, along with a physical exam and STI testing. These tests help identify the most common causes of infertility, such as ovulation disorders, low sperm quality, or blocked fallopian tubes.
While these initial evaluations are critical, they can sometimes overlook subtler or more complex issues. For example, hormone panels may show levels within the “normal” range but fail to reveal imbalances that interfere with egg quality or implantation. Similarly, a semen analysis may look normal yet miss functional problems like DNA fragmentation or oxidative stress in sperm.
Other overlooked factors can include mild endometriosis that isn’t visible on ultrasound, autoimmune or inflammatory conditions affecting implantation, or subtle sperm quality issues. These underlying factors may prevent conception but remain undetected with basic testing.
Emerging research also suggests the vaginal microbiome could be a hidden factor. Imbalances in the vaginal microbiome can cause inflammation and increase infection risk, creating a less favorable environment for conception and embryo implantation. This is why many couples explore advanced fertility testing, which can uncover issues beyond the scope of standard protocols and guide more tailored treatment strategies.
Can you still get pregnant with unexplained infertility? Treatments and next steps.
Fertility treatments can help overcome unexplained infertility. The most common options include:
Assisted reproductive technology
Assisted reproductive technology (ART) treatment helps individuals or couples conceive when natural conception is difficult or unlikely. ART involves handling eggs, sperm, or embryos in a laboratory setting to increase the chances of pregnancy. Common ART procedures include:
- In vitro fertilization (IVF): IVF is a widely used fertility treatment where eggs and sperm are combined in a lab, and resulting embryos are transferred into the uterus. IVF is often recommended for couples with unexplained infertility.
- Artificial insemination: Intrauterine insemination (IUI) involves placing sperm directly into the uterus around the time of ovulation to increase the chances of fertilization. While it can be a less invasive option than IVF, research suggests that IUI may not be as effective for unexplained infertility.
- Intracytoplasmic sperm injection (ICSI): ICSI is an advanced IVF technique where a single sperm is directly injected into an egg. It may help when standard IVF has not resulted in fertilization.
- Donor eggs or sperm: For those who struggle to conceive with their eggs or sperm, using donor eggs, sperm, or embryos can be a viable alternative. This option can be particularly helpful for same-sex couples or individuals pursuing single parenthood.
Medications
Fertility drugs like clomiphene, letrozole, or gonadotropins are sometimes used to stimulate egg production in conjunction with treatments like IUI. However, since ovulation isn’t typically an issue in unexplained infertility, their effectiveness may be limited.
Lifestyle changes
While lifestyle changes can’t guarantee conception, they can improve overall reproductive health and create a more favorable environment for pregnancy. Since unexplained infertility has no clear cause, adopting a more holistic approach to your health may increase your chances of conceiving naturally or with fertility treatments. Here’s how:
- Limit caffeine and alcohol intake
- Avoid smoking and recreational drugs
- Manage chronic stress
- Treat any underlying medical conditions
- Look after your vaginal microbiome.
Making changes to your lifestyle might not solve unexplained infertility by itself, but it can definitely help improve your reproductive health, support any medical treatments, and boost your overall well-being. Many couples facing unexplained infertility end up conceiving naturally with time. By taking positive steps, you can increase your chances of success and feel better along the way. Adopting healthier lifestyle habits can improve your overall well-being, but remember that infertility is never your fault.
The role of microbiome and testing in treatment
New research is showing us just how important the vaginal and reproductive tract microbiome is when it comes to fertility. A balanced microbiome (one with plenty of beneficial Lactobacillus bacteria) creates a welcoming environment for sperm, helps with embryo implantation, and supports early pregnancy. On the flip side, if there are disruptions, like bacterial imbalances or infections, it can lead to inflammation and make it harder for implantation to occur, which might contribute to unexplained infertility.
That’s where Evvy comes in. With our vaginal microbiome testing, you can dive deeper into your unique microbial profile through the Fertility Insights feature. This tool helps you and your doctor spot any imbalances that standard fertility tests might overlook. By addressing these often-hidden factors, Evvy can support you in building a healthier foundation for conception and make your fertility journey much more tailored to your needs.
What to do after multiple failed IUIs
After several unsuccessful IUI attempts with unexplained infertility, it's completely understandable to feel discouraged. While it might be tempting to move straight to IVF or lose hope, this moment can also be an opportunity for a new approach. Sometimes, taking a step back to consider more advanced diagnostic testing — going beyond the standard fertility evaluation — can make a real difference. Standard tests may miss hidden factors like genetic differences, changes in sperm or egg quality (such as DNA fragmentation), subtle uterine receptivity issues, or even immune and endometrial factors.
Exploring targeted assessments like genetic screening, endometrial receptivity profiling, or thorough sperm function tests can help you understand what might be going on and allow for more personalized care. This proactive path can sometimes improve your chances, help you avoid unnecessary costs with IVF, and open up new options tailored just for you, even before considering IVF.
Moving forward with unexplained infertility
Receiving a diagnosis of unexplained infertility can be emotionally challenging. However, it’s important to remember that there are still options available. Whether through lifestyle habits, fertility treatments, or alternative paths to parenthood, many infertile couples and individuals successfully build their families despite an unclear diagnosis.
FAQ
What is the main cause of unexplained infertility?
The main cause of unexplained infertility is unknown because standard fertility tests fail to identify a specific issue. However, researchers and fertility specialists believe it may be due to subtle or undetectable factors affecting conception. Some possible underlying causes include subtle hormonal imbalances, egg or sperm quality issues, implantation challenges, or imbalances in the vaginal microbiome.
Can you get pregnant naturally with unexplained infertility?
Yes. Many couples conceive naturally over time, even without fertility treatments. Fertility isn’t as straightforward as we’re made to believe, so every person (and couple) will have a different experience with an infertility diagnosis. As disheartening as it may be to be told you have unexplained infertility, it’s not impossible to get pregnant (though it may be more challenging).
What should I do after receiving an unexplained infertility diagnosis?
The first step is to recognize that it’s not your fault, nor is it because of something you did or didn’t do. If you don’t have one already, see a fertility specialist (or ask your healthcare provider to refer you to one). They will put together a plan of action — whether that’s ovarian stimulation, in vitro fertilization, intrauterine insemination, or more — tailored to you and your partner’s age, lifestyle, and medical history. They may also recommend lifestyle adjustments to support your overall well-being and boost your chances of conceiving. If you’re struggling with the diagnosis, consider reaching out to support groups or counseling to navigate the emotional impact of infertility. Unexplained infertility affects many couples, so you’re definitely not alone.
Can unexplained infertility be cured?
Unexplained infertility doesn’t have a single “cure,” because by definition, no clear cause has been identified. However, many couples still achieve pregnancy naturally or with treatment. Studies show that 30–80% of couples conceive spontaneously within three years of trying, even without intervention. For others, fertility treatments like ovulation induction with timed intercourse, intrauterine insemination, or IVF can significantly improve chances. Advanced testing may reveal hidden factors such as subtle egg or sperm issues, uterine receptivity problems, or microbiome imbalances, allowing for more targeted treatment. While unexplained infertility itself may not be “resolved,” tailored management often leads to successful outcomes.
What are the risk factors for unexplained infertility?
Several factors are associated with an increased likelihood of receiving an unexplained infertility diagnosis. Age is a key factor as egg quality declines over time. Subtle hormonal imbalances that appear within normal ranges on standard tests may also play a role. Lifestyle choices such as smoking, excessive alcohol use, high stress, or poor diet can negatively affect fertility. In some cases, mild medical conditions like early-stage endometriosis, thyroid disorders, or autoimmune issues may interfere with conception but go undetected. Similarly, sperm may appear normal on a basic analysis, while underlying issues such as DNA fragmentation or oxidative stress reduce male fertility potential.
What are the treatment options for unexplained infertility?
Treatment depends on factors such as age, how long you’ve been trying to conceive, and whether there are other potential risk factors. Many doctors suggest beginning with simple lifestyle changes — like eating healthier, managing stress, and cutting back on smoking or heavy drinking — because these steps can really make a difference. If those changes don’t do the trick, they often recommend methods like ovulation induction along with timed intercourse or intrauterine insemination. These approaches can help boost your chances of fertilization. And if you find that those methods aren’t quite working as hoped, IVF treatment could be a great option to consider. Additionally, there are advanced tests available, such as sperm DNA analysis, endometrial receptivity testing, or microbiome evaluations. These tests can provide valuable insights that lead to more personalized treatment plans, helping to improve your chances of a successful pregnancy.
What should I do after multiple failed IUIs?
After three or more failed rounds of intrauterine insemination, it may be time to revisit your treatment plan and explore additional diagnostic options. Rather than immediately proceeding to IVF, advanced testing can help identify underlying issues that standard infertility testing may have missed. This may include assessing sperm DNA integrity, screening for genetic factors, evaluating endometrial receptivity, or analyzing the vaginal microbiome. These insights can help your care team refine your treatment approach, ensuring that subsequent attempts (whether adjusted medication or IVF) are better targeted. Taking this step not only maximizes your chance of success but also ensures that your time, emotional energy, and financial investment are used effectively.

.avif)